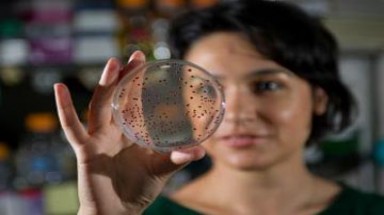
Làm sống lại vi khuẩn 500 triệu tuổi

Công nghệ xanh » Phát minh - Sáng chế
-
 (21:10:10 PM 28/07/2012)
(21:10:10 PM 28/07/2012)(Tin Môi Trường) - Đề tài “Nghiên cứu xây dựng quy trình sản xuất giống và thử nghiệm nuôi thương phẩm cá Chạch sông (Mastacembelus armatus) tại tỉnh Phú Thọ” bước đầu đạt được kết quả rất khả quan, góp phần lưu trữ nguồn gen, tái tạo, phát triển nguồn lợi thủy sản trên địa bàn tỉnh Phú Thọ và mở ra hướng mới để xóa nghèo cho người dân địa phương.
Từ khóa liên quan: Nhân giống, thành công, cá Chạch sông, quý hiếm -
 (10:21:46 AM 27/07/2012)
(10:21:46 AM 27/07/2012)(Tin Môi Trường) - Chỉ cần bấm nút, máy sẽ tự động thực hiện đo huyết áp mà không cần phải thực hiện thêm thao tác nào. Các thông số đo sẽ được hiển thị trên màn hình LCD của máy, và truyền tới bác sĩ qua mạng internet.
Từ khóa liên quan: Máy đo, huyết áp, tự động -
(16:03:20 PM 16/07/2012)
(16:03:20 PM 16/07/2012)(Tin Môi Trường) - Đây không phải bộ phim khoa học về Công viên kỷ Jura, mà là điều đang được thực hiện tại Viện Công nghệ Georgia (Mỹ).
Từ khóa liên quan: Làm, sống lại , vi khuẩn , 500 triệu tuổi -
 (16:00:15 PM 16/07/2012)
(16:00:15 PM 16/07/2012)(Tin Môi Trường) - Nhóm nhà vật lý học từ trường Đại học Delaware Mỹ và Đại học Quốc gia Chungnam, Đại học Hanyang Hàn Quốc vừa phát triển thành công một hệ thống cảnh báo các đợt phun trào hạt mang năng lượng cao từ trong các cơn bão mặt trời mạnh.
Từ khóa liên quan: Hệ thống, cảnh báo , bão mặt trời, mới -
 (11:58:59 AM 12/07/2012)
(11:58:59 AM 12/07/2012)(Tin Môi Trường) - Nghe có vẻ buồn cười nhưng trên thực tế, đó là thắc mắc chưa từng có một câu trả lời cụ thể. Mới đây, các nhà khoa học cho biết, họ đã tìm ra lý do tại sao loài chó lại thích ăn thịt và gặm xương.
Từ khóa liên quan: tại sao, chó thích, gặm xương, mẫu xương -
 (08:24:35 AM 09/07/2012)
(08:24:35 AM 09/07/2012)(Tin Môi Trường) - "Chúng tôi gọi đó là các điểm X (X-points) hoặc các vùng khuếch tán electron, nơi từ trường của Trái đất và từ trường của Mặt trời gặp nhau".
Từ khóa liên quan: cổng nối , Mặt trời , Trái đất, từ trường, khí quyển, bão từ -
 (11:52:15 AM 08/07/2012)
(11:52:15 AM 08/07/2012)(Tin Môi Trường) - Các nhà thiên văn Đức vừa tìm thấy một hệ hành tinh có kiểu phân bố giống Thái Dương Hệ, với những hành tinh đá ở phía trong và những hành tinh khí ở phía ngoài.
Từ khóa liên quan: phát hiện , phiên bản, song sinh , hệ Mặt Trời -
 (15:32:09 PM 06/07/2012)
(15:32:09 PM 06/07/2012)(Tin Môi Trường) - Tổ tiên gần nhất của dòng giống con người có thể đã sống qua ngày bằng cách ăn lá, quả và vỏ cây của núi rừng thay vì một thực đơn dựa vào đồng cỏ như những họ hàng tuyệt chủng khác của loài người.
Từ khóa liên quan: nhân loại , đến, từ rừng núi, tổ tiên, loài người -
 (14:51:28 PM 27/06/2012)
(14:51:28 PM 27/06/2012)(Tin Môi Trường) - (Tinmoitruong.vn) - Với khả năng sáng tạo, ham học của mình, nhiều sinh viên (SV) Trường ĐH Khoa học tự nhiên TP.HCM nghĩ ra những ý tưởng thú vị với hy vọng góp phần nâng cao chất lượng cuộc sống.
Từ khóa liên quan: Ý tưởng, độc, sinh viên -
 (10:51:45 AM 27/06/2012)
(10:51:45 AM 27/06/2012)(Tin Môi Trường) - (Tinmoitruong.vn) - Rút ngắn thời gian sản xuất nước mắm còn 6 tháng, thay vì 10-12 tháng như trước đây. Thu được lượng nước mắm cốt nhiều hơn 30% sới với sản xuất theo truyền thống. Tất cả lợi ích trên là nhờ... năng lượng mặt trời”.
Từ khóa liên quan: sản xuất nước mắm, năng lượng mặt trời -
 (10:56:33 AM 14/06/2012)
(10:56:33 AM 14/06/2012)(Tin Môi Trường) - (Tinmoitruong.vn) - Công nghệ mới cho phép người dùng rút tiền từ các máy ATM bằng điện thoại di động thay vì dùng thẻ từ hoặc thẻ chip như hiện tại.
Từ khóa liên quan: ATM, không, cần thẻ -
 (14:59:17 PM 12/06/2012)
(14:59:17 PM 12/06/2012)(Tin Môi Trường) - (Tinmoitruong.vn) - Khi một cơn bão đang tiến tới, nếu như phải chờ lệnh sơ tán thì chúng ta thường lâm vào cảnh kẹt đường hàng giờ. Nhưng chuyện gì sẽ xảy ra nếu bạn có thể tính toán được mối nguy hiểm và ra quyết định sớm hơn? Một chiếc máy tính toán cơn bão đã được ra đời vào tuần này tại Houston, hứa hẹn sẽ giúp cư dân giải quyết tình trạng này.
Từ khóa liên quan: máy đo bão, công nghệ xanh, bão Rita, Houston -
 (09:26:04 AM 09/06/2012)
(09:26:04 AM 09/06/2012)(Tin Môi Trường) - (Tinmoitruong.vn) - Một giáo viên robot khả năng giám sát mức độ tập trung của học sinh và thu hút sự chú ý của bọn trẻ hứa hẹn sẽ chấm dứt tình trạng ngủ gật.
Từ khóa liên quan: giáo viên, robot, học sinh -
.jpg) (10:25:28 AM 07/06/2012)
(10:25:28 AM 07/06/2012)(Tin Môi Trường) - (Tinmoitruong.vn)- "Chúng tôi không biết mơ tỉnh có đem lại lợi ích tâm lí nào không nhưng tôi có thể đảm bảo với bạn rằng hiện tượng này có tác dụng giải trí cao, giống như bạn được đi xem phim mà không mất tiền vé".
Từ khóa liên quan: giấc mơ, như ý muốn, công nghệ -
 (08:16:31 AM 30/05/2012)
(08:16:31 AM 30/05/2012)(Tin Môi Trường) - Nhiều năm gần đây, tình trạng sóc cắn phá trái ca cao gây thiệt hại nặng nề đối với hàng ngàn hộ nông dân trồng loại cây này tại Bến Tre, địa phương có diện tích ca cao lớn nhất nước. Tuy nhiên, việc ngăn chặn, hạn chế sự phá hoại của loài gặm nhấm này vẫn gặp không ít khó khăn. Nguyên nhân chính là không có phương pháp thật sự hữu hiệu, trong khi những cách truyền thống như đặt bẫy, đánh bả, xua đuổi rất kém hiệu quả.
Từ khóa liên quan: Biện pháp, đơn giản , ngừa, sóc, cắn phá, ca cao -
 (13:33:17 PM 28/05/2012)
(13:33:17 PM 28/05/2012)(Tin Môi Trường) - (Tinmoitruong.vn)- Một nhà máy hạt giống cây trồng ở Mỹ đã sáng tạo ra loại bắp 7 màu đặc sắc, và chúng chỉ "chuyển màu" như vậy khi được nấu chín.
Từ khóa liên quan: Lai tạo, thành công, giống ngô, lạ, chuyển 7 màu , nấu chín -
(11:55:19 AM 28/05/2012)
(Tin Môi Trường) - (Tinmoitruong.vn)-Một, hai, ba, bắn! Những quả tên lửa xanh đỏ cánh bằng giấy bồi bay vút lên trong tiếng hò reo vang dậy của bọn trẻ. Tên lửa được đẩy lên không trung nhờ động cơ là nước và không khí.
Từ khóa liên quan: tên lửa nước, ước mơ, học sinh -
 (17:42:37 PM 26/05/2012)
(17:42:37 PM 26/05/2012)(Tin Môi Trường) - (Tinmoituong.vn)- Thoạt nghe như trong phim khoa học viễn tưởng, nhưng đó là thực tế. Các nhà khoa học Mỹ mới đây tuyên bố đã tìm được cách biến tế bào sống thành thiết bị lưu trữ dữ liệu kỹ thuật số, một dạng “ổ cứng sống”.
Từ khóa liên quan: tế bào sống, bộ nhớ, sinh học -
 (09:11:02 AM 19/05/2012)
(09:11:02 AM 19/05/2012)(Tin Môi Trường) - Chi cục thủy sản Tuyên Quang đang thực hiện dự án “Ứng dụng tiến bộ kỹ thuật sản xuất giống cá Lăng chấm bằng phương pháp sinh sản nhân tạo”.
Từ khóa liên quan: Sản xuất , giống, cá Lăng chấm , sinh sản, nhân tạo -
 (09:59:07 AM 14/05/2012)
(09:59:07 AM 14/05/2012)(Tin Môi Trường) - (Tinmoitruong.vn) - Đồng hồ là một vật dụng không thể thiếu đối với mỗi chúng ta. Một chiếc đồng hồ đơn thuần chỉ là để xem giờ, nhưng nghệ sỹ Dominic Wilcox có thể làm được nhiều hơn thế.
Từ khóa liên quan: Dominic Wilcox, tạo hình, đồng hồ, độc đáo, khó tin -
 (19:48:30 PM 08/05/2012)
(19:48:30 PM 08/05/2012)(Tin Môi Trường) - (Tinmoitruong.vn)- Các nhà khoa học Mỹ vừa công bố phát hiện 24 loài thằn lằn mới ở các hòn đảo thuộc vùng Caribe, tuy nhiên khoảng một nửa các loài này hiện đang có nguy cơ tuyệt chủng.
Từ khóa liên quan: thằn lằn , phát hiện , vùng Caribe -
 (08:25:12 AM 08/05/2012)
(08:25:12 AM 08/05/2012)(Tin Môi Trường) - (Tinmoitruong.vn) - Viện Công nghệ, Tổng cục Công nghiệp Quốc phòng đã chế tạo thành công áo giáp chống đạn đạt tiêu chuẩn của Mỹ.
Từ khóa liên quan: Việt Nam, áo chống đạn, quân đội Việt Nam -
 (08:49:54 AM 07/05/2012)
(08:49:54 AM 07/05/2012)(Tin Môi Trường) - (Tinmoitruong.vn) - Chiếc "gương thần" này không chỉ dùng để soi mà còn được kết nối Internet để thông tin tình hình thời tiết và tin tức, kiểm tra tin nhắn hoặc phản hồi từ mạng xã hội.
Từ khóa liên quan: Kết nối , Internet , với "Gương thần", công nghệ mới

Học viện Y - Dược học Cổ truyền Việt Nam bổ nhiệm 10 Phó Giáo sư năm 2025
(Tin Môi Trường) - Chiều 11/12, Học viện Y- Dược học Cổ truyền Việt Nam tổ chức Lễ công bố và trao quyết định bổ nhiệm chức danh Giáo sư, Phó Giáo sư năm 2025. Năm nay, Học viện có 10 nhà giáo được bổ nhiệm chức danh Phó Giáo sư – những chuyên gia giàu kinh nghiệm trong các lĩnh vực có ảnh hưởng trực tiếp đến sức khỏe cộng đồng và hệ sinh thái y tế như Nội khoa, Nhi khoa, Ung bướu, Tai mũi họng, Ngoại khoa, Chẩn đoán hình ảnh và Y học cổ truyền.
- Hàng loạt khách sạn và cơ sở lưu trú Việt Nam bị tấn công qua email chứa virus, giả mạo Booking.com
- Tiến sĩ người Việt được vinh danh tại Đức vì đóng góp xuất sắc cho nghiên cứu khoa học truyền thông về thiên tai và khủng hoảng
- Lỗ hổng nền tảng thương mại điện tử của Adobe đang bị khai thác mạnh, doanh nghiệp Việt Nam cần khẩn trương ứng phó


Nghiên cứu đề xuất giải pháp quản lý ô nhiễm “dầu khó nhận biết” được đánh giá cao
(Tin Môi Trường) - Tổng Thư ký Hội Bảo vệ TN&MT Việt Nam, Thạc sỹ Phạm Văn Sơn cùng các cộng sự Trung tâm ứng phó sự cố môi trường SOS và Trường Đại học Thái Nguyên vừa công bố Đề tài Nghiên cứu và đề xuất giải pháp quản lý ô nhiễm “dầu khó nhận biết” đã nhận được nhiều ý kiến đánh giá cao của các chuyên gia và cộng đồng.

Siemens Việt Nam và tập đoàn AIT ra mắt SIVACON S8: Thúc đẩy số hóa và định hình tương lai năng lượng Việt Nam
(Tin Môi Trường) - Chiều ngày 28/11/2025, tại TP. Hồ Chí Minh, Siemens Việt Nam phối hợp cùng tập đoàn AIT chính thức ra mắt tủ điện SIVACON S8 – tủ phân phối với công nghệ số hóa thế hệ mới – tại thị trường Việt Nam. Sự kiện này đánh dấu bước hợp tác chiến lược giữa Siemens và AIT trong chuyển giao công nghệ và sản xuất nội địa, khẳng định cam kết chung trong việc phát triển hạ tầng năng lượng quốc gia.
.jpg)

 Trợ giúp |
Trợ giúp | Site map |
Site map |




































